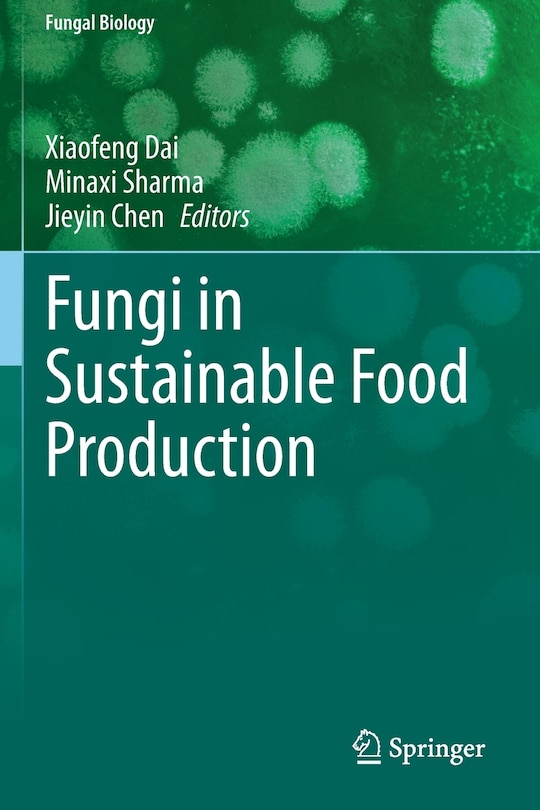
Couverture_Fungi in Sustainable Food Production

Aperçu gratuit du livre Fungi in Sustainable Food Production
160,95 $
Prix en ligne. Les prix et les offres peuvent différer en magasin.
M’expédier cet article
Vérification des stocks…
Acheter maintenant et ramasser en magasin
Vérification des stocks…
Trouver en magasin
Vérification des stocks…
Description
Publié par: Springer Nature
Dimensions à l’expédition: 9" H x 6" W x 1" L
ISBN: 9783030644086
Étape de vie: null